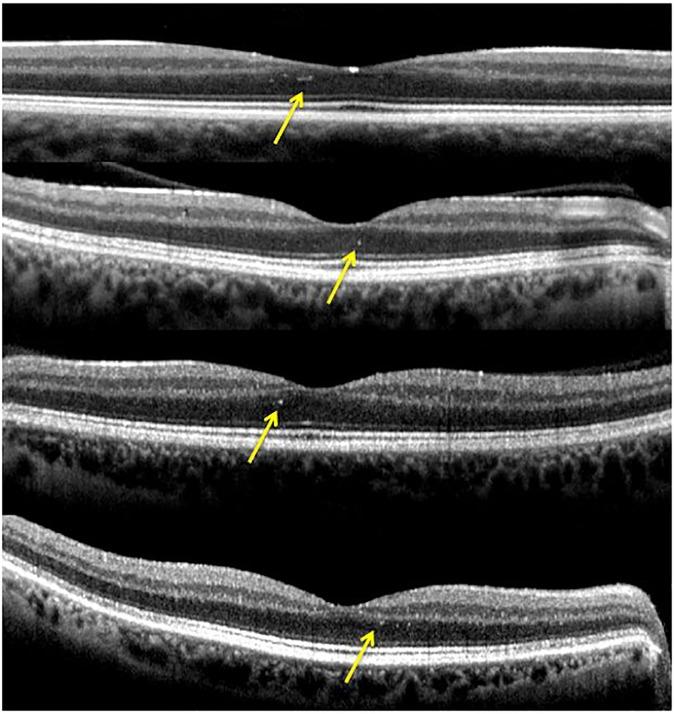
https://cdn.ncbi.nlm.nih.gov/pmc/blobs/a8cb/5373574/1f01d83100d5/pone.0174560.g004.jpg

通过频域光学相干断层扫描和微视野检查评估显性遗传性视神经萎缩患者的视网膜后极部
Assessment of the retinal posterior pole in dominant optic atrophy by spectral-domain optical coherence tomography and microperimetry.
作者信息
Cesareo Massimo, Ciuffoletti Elena, Martucci Alessio, Sebastiani Jacopo, Sorge Roberto Pietro, Lamantea Eleonora, Garavaglia Barbara, Ricci Federico, Cusumano Andrea, Nucci Carlo, Brancati Francesco
机构信息
Ophthalmology Unit, Department of Experimental Medicine and Surgery, University of Rome "Tor Vergata", Italy.
Laboratory of Biometry, Department of Systems Medicine, University of Rome "Tor Vergata", Rome, Italy.
出版信息
PLoS One. 2017 Mar 30;12(3):e0174560. doi: 10.1371/journal.pone.0174560. eCollection 2017.
BACKGROUND
To assess posterior pole (PP) retinal structure in patients with genetically confirmed autosomal dominant optic atrophy (ADOA) using new spectral domain optical coherence tomography (SD-OCT) segmentation technology. To analyze retinal PP thickness in relation to retinal sensitivity data from microperimetry (MP) in ADOA patients.
METHODS AND FINDINGS
This prospective cross-sectional study included 11 patients with ADOA and 11 age-matched healthy subjects. All participants underwent both a "Posterior Pole" and "peripapillary RNFL (pRNFL)" scanning protocol using SD-OCT. Functional mapping of the PP was also performed using MP. A customized program was implemented in order to achieve accurate superimposition of MP sensitivity map onto SD-OCT map. The thickness of the PP different retinal layers and pRNFL was obtained and measured for each eye. Mean retinal sensitivity values and fixation stability were obtained and compared between ADOA patients and healthy subjects. Correlation analysis was performed on a point-to-point basis to evaluate the association between mean thickness and retinal sensitivity of each retinal layer. Total retinal thickness (TRT), Retinal Nerve Fiber Layer (RNFL), Ganglion Cell Layer (GCL), Inner Plexiform Layer (IPL), Inner Nuclear Layer (INL) and Inner Retinal Layers (IRL) at the posterior pole as well as pRNFL were significantly thinner in ADOA patients (P < 0.0001). On the contrary, the Outer Plexiform Layer (OPL) and the Outer Nuclear Layer (ONL) were significantly thicker in the ADOA group (P < 0.001). No significant differences were found in Retinal Pigment Epithelium (RPE) and Outer Retinal Layers (ORL) thickness between ADOA and controls. The average PP retinal sensitivity was significantly reduced in ADOA patients compared with controls (P < 0.001), as measured by microperimeter Nidek MP-1 (MP1). Fixation stability was significantly worse in the ADOA group (P = 0.01). The most severe sensitivity defects in ADOA patients were found at the level of the papillo-macular bundle (PMB).
CONCLUSIONS
Inner retinal layers showed pathological changes in ADOA patients. In addition, the whole retinal PP (not only the PMB) was significantly altered in ADOA, both in terms of retinal thickness and sensitivity.
背景
使用新的光谱域光学相干断层扫描(SD-OCT)分割技术评估基因确诊的常染色体显性遗传性视神经萎缩(ADOA)患者的后极部(PP)视网膜结构。分析ADOA患者视网膜PP厚度与微视野计(MP)视网膜敏感度数据的关系。
方法与结果
这项前瞻性横断面研究纳入了11例ADOA患者和11例年龄匹配的健康受试者。所有参与者均使用SD-OCT进行了“后极部”和“视乳头周围视网膜神经纤维层(pRNFL)”扫描方案。还使用MP对视乳头周围进行了功能绘图。实施了一个定制程序,以实现MP敏感度图与SD-OCT图的精确叠加。测量了每只眼睛的PP不同视网膜层和pRNFL的厚度。获取并比较了ADOA患者和健康受试者的平均视网膜敏感度值和注视稳定性。进行逐点相关分析,以评估每个视网膜层的平均厚度与视网膜敏感度之间的关联。ADOA患者后极部的视网膜总厚度(TRT)、视网膜神经纤维层(RNFL)、神经节细胞层(GCL)、内丛状层(IPL)、内核层(INL)和视网膜内层(IRL)以及pRNFL均显著变薄(P < 0.0001)。相反,ADOA组的外丛状层(OPL)和外核层(ONL)显著增厚(P < 0.001)。ADOA患者与对照组之间的视网膜色素上皮(RPE)和视网膜外层(ORL)厚度无显著差异。通过Nidek MP-1微视野计(MP1)测量,ADOA患者的平均PP视网膜敏感度与对照组相比显著降低(P < 0.001)。ADOA组的注视稳定性明显较差(P = 0.01)。ADOA患者最严重的敏感度缺陷出现在视乳头黄斑束(PMB)水平。
结论
ADOA患者的视网膜内层出现病理变化。此外,ADOA患者的整个视网膜PP(不仅是PMB)在视网膜厚度和敏感度方面均有显著改变。